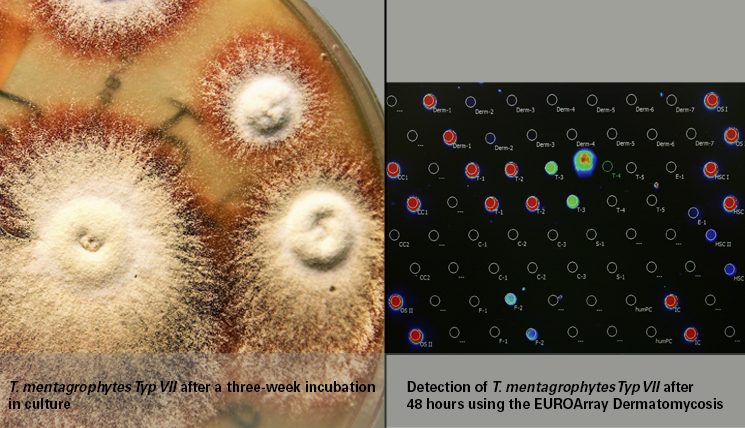

Guest contribution:
Article series on the subject of state-of-the-art mycology in dermatology,
1st article
by Prof Hans-Jürgen Tietz, Director of the Institute of Fungal Diseases in Berlin, Germany
Mycology is one of the most beautiful faces of dermatology. To admire T. soudanense, T. violaceum or T. benhamiae in a Petri dish is an aesthetic enjoyment. Everybody who knows me will tell you how much my heart belongs to the wonderful fungal cultures that mycology has been showing us for decades. At every opportunity I have defended it with great passion and urged not to give it up under any circumstances, also due to its affordability for patients. I have held fast to it for a long time, albeit, in 2001, we had already developed the first gene probe for the detection of T. rubrum from nail material at the Berlin Charité together with our doctoral student Mustafa El Fari from Palestine and published it in the British Journal of Dermatology. However, for a long time, this had been accompanied by our scepticism towards the emerging commercial gene diagnostics: too many false-positive results, too time-consuming, the first systems not well enough developed, a too small range, too imprecise diagnoses such as “Trichophyton species”. At this point, conventional mycologists had produced better results for years, as was shown by many successful quality assessment schemes.
“How come you’ve finally turned from Saul to Paul?,” I was once asked at a mycology seminar in Hannover, at which I enthusiastically presented our first successful PCR results almost three years ago. I later saw the bible quote as a compliment, since the story of Saul is that of a change for the better. It represents, if you like, a change from the venerable culture –wonderfully beautiful but marked by deceptions and disappointments, a sphinx that quite often lets us down considering the high failure rate in onychomycosis – to accurate and fast PCR. Even our teacher, the forensic pathologist Professor Otto Prokop, was thrilled about this method, which was awarded the Nobel Prize in 1993. As the father of blood group serology and a forensic geneticist, he also saw the future of microbiology in gene diagnostics on the occasion of the inauguration of the first DNA laboratory for forensic medicine at the Charité.
The penny only dropped much later, when I was inspired by a laboratory visit to the Dermatological Clinic in Lübeck. There, we admired a beautiful ruby-coloured T. mentagrophytes of type VII (see titel), which my colleagues had already identified weeks earlier by means of PCR, without having to wait for the culture result. This “Thailand fungus” is often resistant to terbinafine, a fact that is relevant for a quick and correct therapy decision. In culture, the pathogen rapidly loses its typical pigmentation and is then no longer recognisable. The PCR, in contrast, remains stable since it is not based on the phenotype but detects the genotype of the pathogen.
The principle of PCR (polymerase chain reaction) is quite simple. Like any other culprit, fungal pathogens leave a trace at the scene of action, namely the infection. This is a genetic trace, i.e. DNA, which can be collected from the sample and biochemically multiplied – the actual PCR – to specifically identify the culprit based on complementary gene sequences. At this point, I was hooked.
My choice fell on the EUROArray Dermatomycosis, a sophisticated microscope slide-based method that has been showered with scientific prizes. It is based on DNA chips and can be performed fully automatically in any practice. One of its significant advantages is the broad test spectrum, comprising all of the dermatologically relevant dermatophytes, yeasts and moulds – a gift from the heavens, considering the continuously increasing pathogen spectrum that mycology is facing.
I admit that this kind of diagnostics has nothing to do with the brilliance of a fantastically beautiful fungal culture. However, it is fast and independent of pathogen cultivation, which is often unsuccessful, and it is uncompromisingly precise. It will also help you to pass any quality assessment scheme without trepidation.
Moreover, PCR has a strategic potential. If more practitioners turned to gene diagnostics, which is economically worthwhile in mycology for the first time, instead of giving up mycology entirely due to the stringent regulatory requirements with respect to cultivation, this would ensure the continued existence of mycology within the field of dermatology.
From a professional point of view, PCR should be in the hands of practice doctors, since it neither starts nor ends in the laboratory. The clinical perspective, professional sampling and plausible classification of test results are irreplaceable, true to the decades-old principle that diagnostics and therapy should be in one hand.
If I was able to turn from Saul to Paul after so many years, you can certainly do the same. I am firmly convinced of this.
We would like to encourage you to embark on the same route and want to accompany you on this exciting journey with a small column.
Sincerely yours,
Hans-Jürgen Tietz
The articles under the rubric “Guest contribution” only reflect the views of the respective authors. Responsibility for the legality and content of the articles lies solely with the authors. EUROIMMUN does not assume liability for the completeness, accuracy and currentness of the information provided.